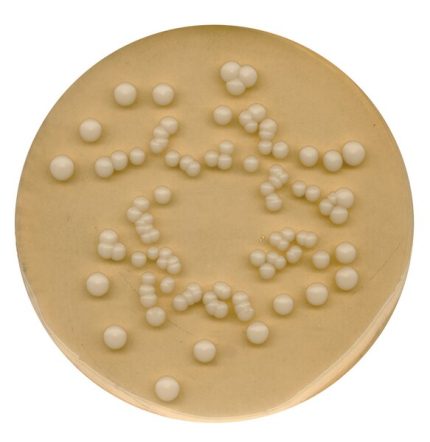
محیط کشت PDA, خرید محیط کشت PDA , فروش محیط کشت PDA , Potato Dextrose Agar, 110130

محیط کشت BGB (Brilliant-green bile Lactose)
فروش محیط کشت BGB (نام کامل: Brilliant-green bile Lactose) با کد 105454 برند مرک اصل با کیفیتی تضمینی در آرمان کیمیا زیست، تامین کننده مواد شیمیایی آزمایشگاهی با بیش از ۳۰ سال سابقه، جهت خرید محیط کشت BGB با ما تماس بگیرید یا شماره تماس خود را وارد نمائید تا کارشناسان فروش در اسرع وقت با شما تماس بگیرند
جدول خصوصیات محلول
| حجم | , , , |
|---|---|
| دیگر نامها |
BRILA (Brilliant-green bile Lactose) broth BRILA (Brilliant-green bile Lactose) broth ,Brilliant-green bile lactose broth, Brillant-green bile lactose broth |
| کد محصول | |
| کشور سازنده |
آلمان |
| کمپانی سازنده |
سیگما الدریچ (Sigma-Aldrich) ,مرک (Merck) |
| pH |
7.2 (40 g/l, H₂O, 30 °C) (after autoclaving) |
محیط کشت BGB چیست؟
محیط کشت BGB – BRILA (Brilliant-green bile lactose) broth یک محیط کشت خاص است که برای شناسایی و کشت باکتریهای کلی فعال در نمونههای کلیه و آب معده استفاده میشود.
این محیط کشت از ترکیباتی مانند زردچوبه سبز خلاء، نمکهای صفراوی، لاکتوز، و دیگر مواد مغذی تشکیل شده است که شرایط مناسبی را برای رشد و شناسایی باکتریهای مورد نظر فراهم میکند.
ویژگیهای فیزیکوشیمیایی
- این محیط کشت دارای رنگ سبز براق است که به دلیل حضور زردچوبه سبز خلاء است.
- pH این محیط کشت معمولاً در محدوده ۷ به ۷٫۵ قرار دارد که شرایط مناسبی را برای رشد باکتریها فراهم میکند.
- حلالیت خوب و امکانات مناسب برای نگهداری در شرایط خنک و خشک.
کاربردها
- استفاده اصلی این محیط کشت در تشخیص و شناسایی باکتریهایی مانند اشریشیاکلی، اشریشیاکلی از گوساله، و سایر باکتریهای کلی فعال است.
- مناسب برای استفاده در آزمایشگاههای پزشکی، آزمایشگاههای بالینی و محیطهای داروسازی برای تشخیص سریع باکتریها.
حجمها و بستهبندی
- این محیط کشت معمولاً در بستهبندیهای مختلف از جمله ۱۰۰ میلیلیتر، ۵۰۰ میلیلیتر و ۱ لیتر عرضه میشود، که این انتخابات متناسب با نیازهای مختلف آزمایشگاهی و بالینی قابل تامین است.

![GranuCult_ISO_17025_stamp[GranuCult_ISO_17025_stamp-ALL] محیط کشت BGB, Brilliant-green bile Lactose , خرید محیط کشت BGB , BRILA](https://armanbio.com/wp-content/uploads/2024/07/GranuCult_ISO_17025_stampGranuCult_ISO_17025_stamp-ALL.jpg)






ایمان –
آیا ارسال به تمام شهرهای ایران بدون محدودیت انجام میشه؟